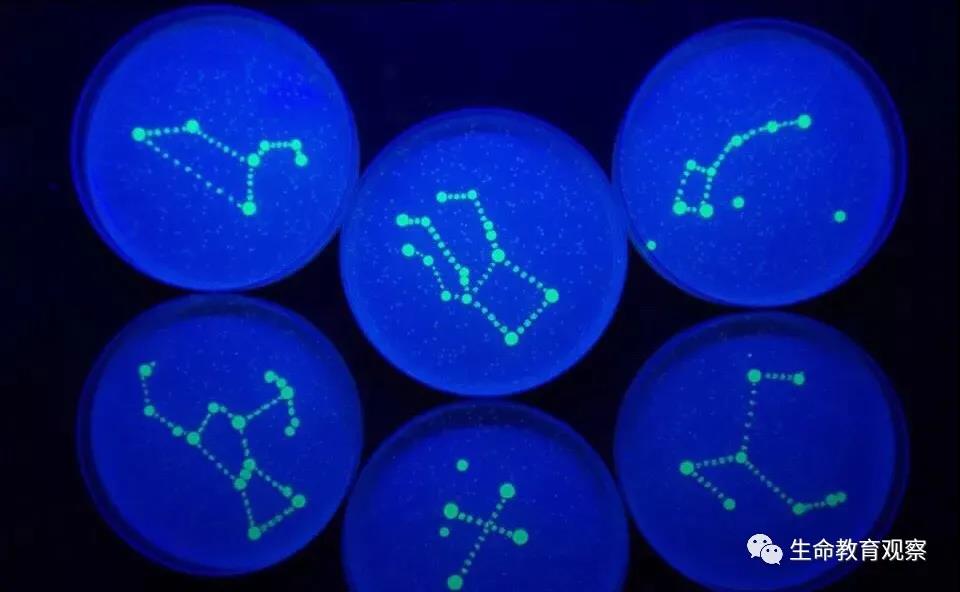
理科男喜欢的七夕礼物,理科男的送的礼物
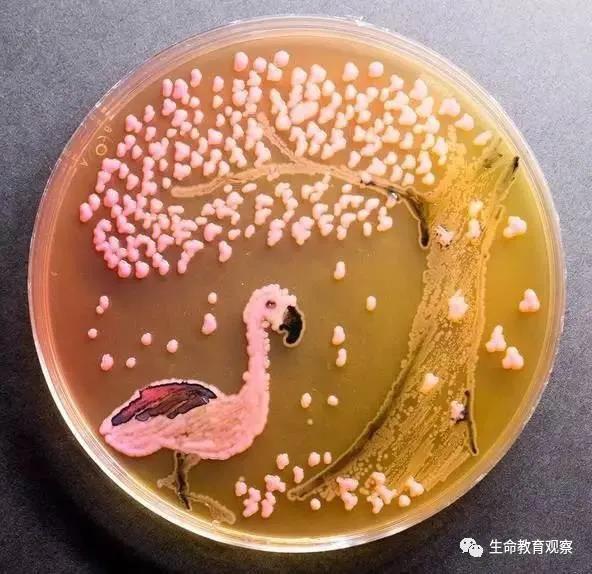
理科男喜欢的七夕礼物,理科男的送的礼物

七夕节到了,你们的理科男朋友都送了怎么样的礼物?理科男普遍都会被标记上直男癌,太过理性,不懂女人心等标签。但是你不知道生物学的学子们还有这么一大技能:为你做的最浪漫的事就是在培养基上为你作画!

在今年,美国微生物学会的培养皿绘画大赛已经办到了第四届啦。上图是这一届的冠军作品冬春之战(The Battle of Winter and Spring)作者:Ana Tsitsishvi。白色的“冬天”由葡萄球菌与蕈状芽孢杆菌组成,春天的一侧含有微球菌以及红酵母菌。
此外还有很多很多往届的优秀作品,话不多说直接上图